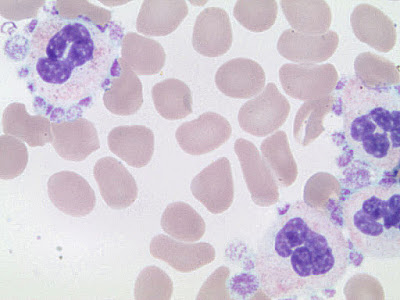

Pseudothrombocytopenia (PTCP) is an in vitro phenomenon of a spuriously reported low platelet count, typically caused by EDTA-dependent platelet aggregation. PTCP has no clinical significance, but misdiagnosis may lead to unnecessary diagnostic tests and treatment. In this study, two cases of EDTA-dependent PTCP are discussed to emphasize the importance of differentiating PTCP from true thrombocytopenia. The first case is of a 77-year-old woman with a femoral neck fracture, and the second case is of a 66-year-old woman with a frozen shoulder. Both cases showed low platelet counts in their routine blood tests and were ultimately proven to have PTCP. When identifying a patient with a low platelet count without any hematology disease, family history, and bleeding tendency manifestation, PTCP should also be considered. Re-examining blood samples with tubes containing other anticoagulants and a peripheral blood smear examination can help identify PTCP.
Read more:
EDTA-dependent pseudothrombocytopenia
Platelet satellitism
Source: Formosan Journal of Surgery

No comments:
Post a Comment